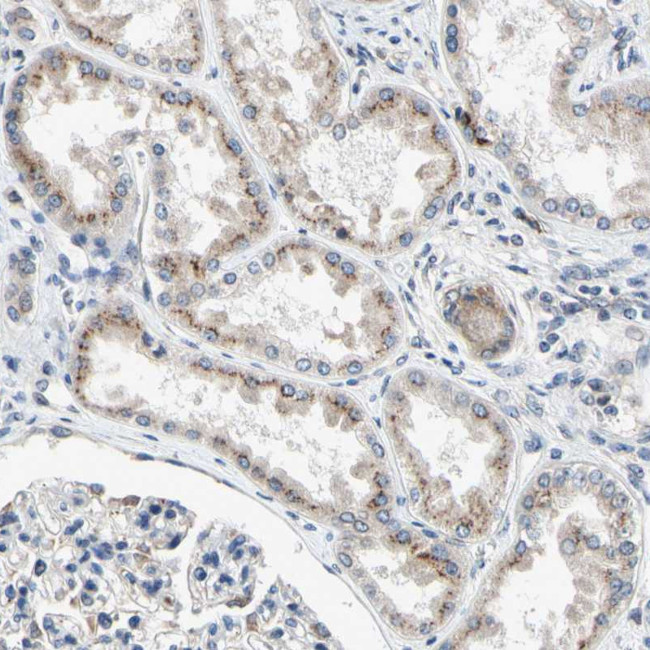
p27 Antibody in Immunohistochemistry (Paraffin) (IHC (P))

Search
Invitrogen
p27 Polyclonal Antibody
{{$productOrderCtrl.translations['antibody.pdp.commerceCard.promotion.promotions']}}
{{$productOrderCtrl.translations['antibody.pdp.commerceCard.promotion.viewpromo']}}
{{$productOrderCtrl.translations['antibody.pdp.commerceCard.promotion.promocode']}}: {{promo.promoCode}} {{promo.promoTitle}} {{promo.promoDescription}}. {{$productOrderCtrl.translations['antibody.pdp.commerceCard.promotion.learnmore']}}
产品信息
PA5-52634
种属反应
宿主/亚型
分类
类型
抗原
偶联物
形式
浓度
规格
纯化类型
保存液
内含物
保存条件
运输条件
RRID
产品详细信息
Immunogen sequence: ITFELPDNAK QCFYEDIAQG TKCTLEFQVI TGGHYDVDCR LEDPDGKVLY KEMKKQYDSF TFTASKNGTY KFCFSNEFST F
Highest antigen sequence identity to the following orthologs: Mouse - 98%, Rat - 99%.
靶标信息
p27, also known as p27Kip1, is a crucial cyclin-dependent kinase inhibitor (CKI) involved in the regulation of the cell cycle. The p27 protein is encoded by the CDKN1B gene located on chromosome 12 and plays a vital role in controlling cell proliferation by inhibiting cyclin-CDK complexes, particularly cyclin A-CDK2 and cyclin E-CDK2. By regulating these complexes, p27 induces cell cycle arrest at the G1 phase, preventing cells from prematurely entering the S phase. This function is critical for maintaining normal cellular processes and preventing uncontrolled cell division. p27 acts as a tumor suppressor, and its expression is tightly controlled by transcriptional and post-transcriptional mechanisms, including proteasome-mediated degradation. Reduced levels of p27 have been associated with numerous cancers, highlighting its role in tumorigenesis. The regulation of p27 involves signaling pathways such as the PI3K/AKT pathway, impacting its localization and stability in response to extracellular signals.
仅用于科研。不用于诊断过程。未经明确授权不得转售。
篇参考文献 (0)
生物信息学
蛋白别名: p24 family protein gamma-3; p24gamma3; p27; Transmembrane emp24 domain-containing protein 7; transmembrane emp24 protein transport domain containing 7; unnamed protein product
基因别名: CGI-109; p24g3; p24gamma3; p27; Tag; TMED7
UniProt ID: (Human) Q9Y3B3
Entrez Gene ID: (Human) 51014